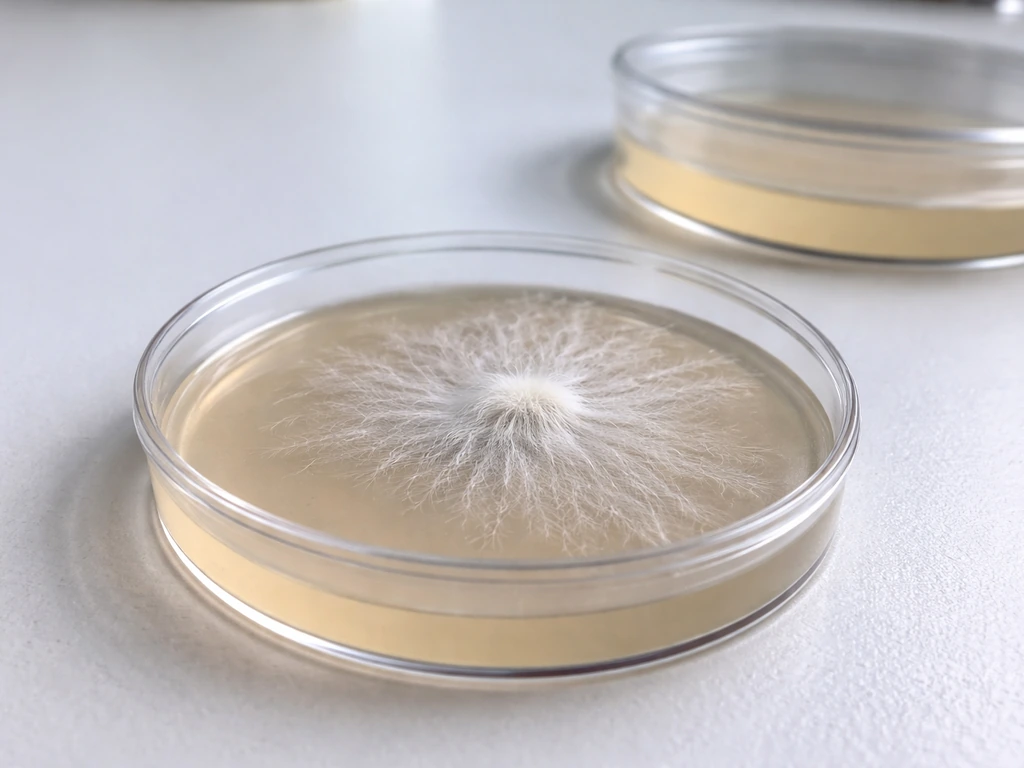
how long does it take for mushroom to grow

Most mushrooms take between 3 and 12 weeks to grow from inoculation to first harvest, depending on the species, whether you start from spores or spawn, and the conditions in your grow space. That range feels wide, but once you understand what's happening at each stage, it becomes much easier to set realistic expectations and spot problems before they cost you a whole crop.
How Long Does It Take to Grow Mushrooms? Timelines
The basic mushroom growth timeline, start to harvest

Every mushroom crop moves through the same core stages: inoculation, colonization (also called spawn run), pinning, and fruiting/harvest. The time spent in each stage adds up to your total grow time. Here's how those stages typically break down for common cultivated species.
| Species | Colonization | Pin to Harvest | Total (Spawn to Harvest) |
|---|---|---|---|
| Oyster (straw) | 14–28 days | 5–12 days | 3–6 weeks |
| Button/Agaricus | ~7–8 weeks from composting start | 15–21 days after casing | 8–12 weeks |
| Shiitake (log) | 6–18 months | Variable per flush | 6–18+ months |
| Shiitake (sawdust) | 21–60 days | 2–3 weeks after colonization | 6–12 weeks |
| Lion's Mane | 21–30 days | 4–5 days | 4–7 weeks |
Oyster mushrooms are the fastest and most forgiving option for beginners. Lion's mane is close behind in total grow time but needs careful CO₂ management during fruiting. Button mushrooms take the longest of the commonly grown edibles when you count the full production cycle from composting through harvest. Shiitake on logs is a long game, but it pays off with multiple years of yields from a single set of logs.
Growing from spores vs from spawn: the timelines are very different
This is where a lot of new growers get tripped up. Starting from spores and starting from spawn are fundamentally different processes, and the timelines reflect that.
Starting from spores
When you start from spores, you first have to germinate them and develop mycelium into what's called mother spawn. For Agaricus (button mushrooms), mother spawn colonization alone takes around 20 to 21 days. You then use that mother spawn to inoculate commercial spawn, which takes another 12 to 14 days to colonize. Only after that do you move into the actual substrate for your crop. Total time from spore to harvest? You're looking at months, not weeks. This is why most home growers skip spores entirely and start from ready-made grain spawn or plug spawn instead.
If you're specifically interested in how to grow magic mushrooms from scratch, the spore-to-harvest timeline follows similar logic: spore germination adds several weeks to the front end of the grow, and technique matters a lot to avoid contamination during those early stages.
Starting from spawn
Starting from pre-made spawn cuts weeks off your timeline. You're skipping the spore germination and mother spawn stages and jumping straight to inoculating your substrate. For oyster mushrooms on straw, spawn run (colonization) takes 14 to 28 days, and with a measured average closer to 19 days in controlled conditions. Most specialty mushrooms on sawdust colonize in about 21 days according to Cornell's stage framework for commercial cultivation. After full colonization, you still need pinning and fruiting time, but you've already saved yourself a month or more compared to starting from spores.
Button mushrooms: how many days, really?

Button mushrooms (Agaricus bisporus) have one of the more complex timelines of any cultivated species because their production cycle involves composting, pasteurization, inoculation, spawn run, casing, and then multiple harvest flushes. Penn State Extension puts the total time from the start of composting to first harvest at about 7 to 8 weeks. After casing, harvest typically begins 15 to 21 days later, which breaks down further: pins form around 13 to 20 days after casing, and the harvest window opens roughly 18 to 21 days in.
The good news is that once harvest starts, you don't just get one picking day. Button mushrooms come in flushes, with a new flush roughly every 10 to 12 days. Most growers get three to five flushes from a single bed before the substrate is exhausted. So when someone asks how long button mushrooms take to grow, the honest answer is: about 8 weeks to your first harvest, then ongoing flushes for another 4 to 6 weeks after that. For a much deeper look at the flush-by-flush timeline, how long does it take to grow shiitake mushrooms uses a similar flush-based structure that's worth reading alongside button timelines.
Wild mushrooms vs cultivated: a completely different clock
Wild mushrooms don't follow your schedule. They respond to environmental cues: rain, temperature swings, humidity, and seasonal changes. In outdoor or forest settings, a mushroom can go from invisible to fully grown in 24 to 48 hours after rain, but the mycelium in the substrate may have been developing for months before that flush happens. You can't really measure 'how long it takes' for a wild mushroom to grow the same way you measure a cultivated crop, because the mycelial network was already there waiting for the right trigger.
For outdoor cultivated species like turkey tail, the situation is somewhere in between. You're working with inoculated logs or wood chips, but you're still dependent on seasonal conditions for fruiting. Cornell notes that outdoor mushroom beds can be expected to fruit every few weeks after rain or heavy watering, which is consistent with how wild populations behave. If you want to go deeper on an outdoor species, how to grow turkey tail mushroom covers the full outdoor cultivation process. For timeline expectations specifically, how long does it take to grow turkey tail mushrooms gives you realistic numbers for what to expect from a log or chip bed.
Controlled indoor cultivation removes the weather variable. You set the temperature, humidity, CO₂ levels, and light cycle yourself, which means you can actually predict and plan your harvest windows. This is the biggest practical advantage of indoor growing over foraging or outdoor beds.
Mushroom spawn timing: what happens before fruiting
The spawn run is the colonization phase, where your mycelium is spreading through the substrate in the dark, building up the network it needs before it can fruit. This stage gets overlooked by growers in a hurry, but it's the foundation everything else builds on. Rush it or disrupt it, and you'll either get poor yields or no fruiting at all.
For oyster mushrooms, USDA SARE recommends incubation at around 75°F for approximately 3 weeks. For shiitake on logs, the spawn run can take 6 to 18 months depending on log diameter and environmental conditions. On prepared sawdust blocks, that same shiitake colonization drops to 30 to 60 days. The substrate and format you choose has an enormous effect on how long this phase takes.
Once colonization is complete, fruiting doesn't start automatically. You need to change conditions to trigger it: typically a drop in temperature, an increase in fresh air exchange, and sometimes a cold shock or light exposure. Out-Grow describes this transition as shifting from spawn-run temperatures (around 24°C) down to fruiting temperatures (16 to 18°C) while reducing CO₂ through increased fresh-air exchange. If you skip this transition, the mycelium will just keep sitting there, colonized but not fruiting.
The same spawn-to-fruit logic applies to specialty varieties like wine caps, which fruit on outdoor beds after a multi-week colonization period. If you've ever wondered how long wine cap mushrooms take to grow, the answer depends heavily on whether the spawn has fully run through the wood chip bed before fruiting conditions arrive.
How conditions directly affect your grow time
This is probably the section that will save you the most time (and frustration). Every stage of mushroom growth has an ideal environmental window, and when conditions drift outside that window, everything slows down or stalls entirely.
Temperature
Temperature affects both colonization speed and fruiting trigger. Most species colonize fastest in the 70 to 80°F range (around 21 to 27°C). Drop below that and colonization slows significantly. Fruiting, on the other hand, typically requires cooler temperatures, and for many species that temperature drop is the primary fruiting trigger. Lion's mane, for example, fruits best at 18 to 24°C, and pins develop quickly in that window, reaching harvest in as little as 4 to 5 days once formed.
Humidity
Low humidity is one of the most common reasons pins abort or fail to form. Once you're in the fruiting stage, relative humidity should be in the 85 to 95% range for most species. UC Davis notes that mushrooms require humid environments with fresh air and oxygen to grow properly, and the two are always in tension: the more you open up for fresh air, the more humidity you lose. Managing that balance is a core skill in home cultivation.
CO₂ and fresh air exchange
High CO₂ is a growth suppressant. During colonization, CO₂ builds up naturally in a closed container and actually helps mycelium grow. But during fruiting, elevated CO₂ delays or prevents pinning, and in species like lion's mane, it causes the fruiting body to grow thin and elongated instead of the dense, white pom-pom you're after. Fresh air exchange, even just fanning your fruiting chamber twice a day, makes a measurable difference to both pin formation timing and final quality.
Substrate
The substrate you use affects colonization speed and overall yield potential. Straw colonizes faster than hardwood sawdust for oyster mushrooms, which is why straw is often recommended for beginners who want results quickly. Harder, denser substrates like oak logs support longer production but take much longer to colonize initially. Nutrient-supplemented substrates can speed up colonization but also raise contamination risk if not properly sterilized.
What to do when your mushrooms stop growing
Stalls happen to everyone. The mycelium looks healthy, colonization was complete, but nothing is pinning and weeks are passing. Before you give up on a block or bag, run through this checklist.
- Check CO₂ levels: if your fruiting chamber is too sealed, CO₂ buildup is likely suppressing pinning. Increase fresh-air exchange immediately, even if it means temporarily dropping humidity.
- Check humidity: if the substrate surface looks dry or cracked, pins that were forming may have aborted. Mist the surface, add a humidity tent, or increase your misting frequency.
- Try a cold shock: move the colonized block to a refrigerator at 4 to 10°C for 12 to 24 hours, then return it to fruiting conditions. This mimics the temperature drop that triggers fruiting in nature.
- Check your temperature: if your grow space is running too warm (above 26°C for most fruiting species), pin formation will be delayed or absent. Bring temps down to the species-appropriate fruiting range.
- Expose to indirect light: many species use light as a directional cue for pin formation. Total darkness during fruiting can delay pinning even when all other conditions are right.
- Scratch or scrape the surface: for blocks that have been sitting colonized for more than 2 weeks without pinning, lightly scratching the surface can stimulate pin formation by exposing fresh mycelium to fruiting conditions.
- Check for contamination: green, black, or pink patches are mold. If contamination is present, the block is unlikely to fruit and should be removed to protect other grows.
Maverick Myco's troubleshooting framework points to CO₂ buildup and missing fruiting triggers (cold shock, light, fresh air) as the two most common reasons a fully colonized block refuses to pin. In my own grow room, CO₂ buildup has been the culprit more times than I'd like to admit, usually because I sealed a fruiting chamber too well and didn't fan it enough. The fix is almost always simple once you identify the cause.
If you've been through the checklist and things still aren't moving, it's worth revisiting your timeline expectations. Oyster mushrooms pin 2 to 3 weeks after full colonization, then reach harvest about 4 days after visible pinning. For chestnut mushrooms, pinning to harvest runs 14 to 18 days. And as a general rule, once pins form, harvest is 5 to 12 days away for most species. If you're well past those windows, the block may be spent or contaminated.
Specialty and psilocybin varieties: their timelines work differently
It's worth briefly noting that psilocybin-containing mushrooms follow the same biological stages as other fungi (colonization, pinning, fruiting), but the legal context varies significantly by location. If you're in a region where cultivation is permitted and you're researching grow times, how long does it take to grow magic mushrooms covers the specific timelines for those species, and how long does it take to grow psychedelic mushrooms addresses the broader category. Magic truffles follow a different growth pattern entirely, since you're harvesting the sclerotia rather than the fruiting body, so how long to grow magic truffles is its own separate timeline question.
Realistic expectations for your first grow
If you're just getting started, pick oyster mushrooms. They give you the fastest feedback loop (3 to 6 weeks from spawn to harvest), they're tolerant of imperfect conditions, and they're genuinely delicious. From there, you'll have a much better feel for how each stage looks and feels before moving to slower, more demanding species like shiitake or button mushrooms.
The single most useful thing you can do to improve your grow time is control your environment consistently. A stable temperature, regular misting, and daily fresh-air exchange will get you to harvest faster and with better yields than any shortcut or additive. Get those basics right, and the timeline takes care of itself.
FAQ
My mushrooms are late, how do I tell if it’s a normal delay or a real problem?
If your grow is several days to a week later than the typical window, don’t panic immediately. First confirm you actually entered the fruiting stage (temperature drop plus fresh-air exchange). Then check humidity (85 to 95% target for most species) and CO₂ (fruiting chambers should not be sealed tight). A block can look healthy during the spawn-run but still stall pins if the fruiting trigger conditions were delayed or too mild.
What are the most common reasons the timeline stretches even when colonization looked complete?
Most delays happen for reasons unrelated to spawn quality. In general, check CO₂ and fresh-air exchange first (high CO₂ is the fastest way to prevent pinning), then verify the humidity range, and finally confirm the temperature transition into fruiting. If those are correct and colonization is complete, re-check your timeline for that species format (for example, logs can be months at spawn-run, sawdust blocks are much faster).
When someone says “x weeks,” what starting point are they usually counting from?
“From inoculation” can mean different starting points. In cultivation terms, time can be counted from when you inoculate the substrate, or from when you add spores, or from when you begin fruiting conditions. If you’re comparing growers’ numbers, ask what the baseline event was, and whether they started from spawn or spores, because spore-to-harvest includes extra germination and mother-spawn steps.
How much should I expect the time to vary between grows?
Yes, the same species can vary a lot depending on how you prepare the substrate and manage the environment. For example, colder rooms slow colonization, and inconsistent misting or fresh-air exchange slows fruiting or causes malformed fruits. Substrate form matters too, straw versus sawdust, and thicker or denser materials generally take longer to colonize.
If I already have pins, how do I estimate when I’ll harvest?
A good rule is to treat “first pins” as your new reference point. Once visible pins appear, most species finish harvest relatively quickly, often within about a week for many edibles, though the exact number depends on the species. If pins never appear after you have verified fruiting conditions and CO₂ control, the block is likely stalled rather than just “slow.”
Do I need to keep conditions more stable during spawn run or during fruiting?
During colonization, disrupting the environment is more harmful than small day-to-day swings in fruiting. Keep the substrate dark and stable during spawn run, and avoid frequent opening that lets conditions vary. During fruiting, the main “musts” are fresh air, humidity, and the temperature shift, because those directly control pin initiation and development.
What signs indicate contamination versus a stalled block that just needs a better trigger?
You can tell a fruiting stall from an early contamination issue by appearance and progress. Contamination often spreads as unusual growth colors, odors, or patchy areas that don’t develop into normal mycelium patterns. A stalled, healthy-looking block usually still shows no pins even though it is fully colonized, and the trigger conditions (fresh air, temperature drop, light, and CO₂) are the likely culprits.
What’s the fastest path to get mushrooms in hand for a first-time grower?
For beginners, the most practical way to shorten time is to choose spawn that already passed the slow initial stages, like ready-made grain spawn or appropriate plugs, instead of starting from spores. Also, pick a fast starter species such as oysters, and prioritize consistent environment control (temperature stability, humidity management, and daily fresh-air exchange).
Does “time to harvest” include multiple flushes, or just the first one?
Yes. For example, button production includes composting and multiple harvest flushes, so the first harvest timing is not the whole story, and subsequent flushes add extra weeks. If you judge success by only the first harvest, you might underestimate total production time compared with species that fruit in a shorter, simpler pattern.
Do I always need cold shock to trigger fruiting, or can I rely on humidity and fresh air?
A “cold shock” is not always required, but a temperature transition into the fruiting range is usually essential. If you can’t drop temperature, you may still succeed by improving fresh-air exchange and CO₂ control, but you might get delayed or lower pinning rates. The best approach is to aim for the documented fruiting temperature window for your species rather than using an aggressive shock by guesswork.
